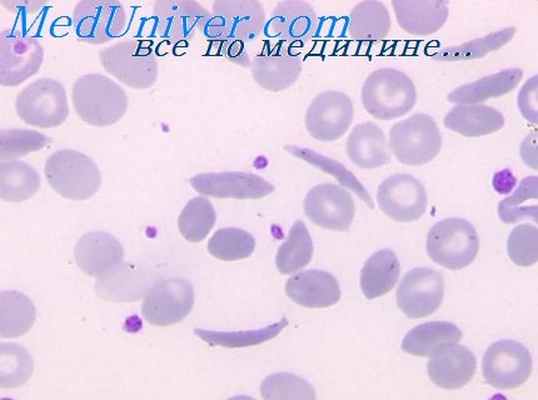
серповидно-клеточная анемия

Серповидно-клеточная анемия. Гидроксимочевина
Добавил пользователь Alex Обновлено: 02.11.2025
Серповидно-клеточная анемия. Гидроксимочевина
Серповидно-клеточная анемия является частой гемоглобинопатией в основном у представителей негроидной расы. Пятьдесят лет назад Лайнус Поллинг и его коллеги открыли, что серповидноклеточная анемия вызывается белковой молекулой, кодируемой определенным геном. Точный механизм был выяснен позднее: точечная мутация в Р-цепи гена гемоглобина S приводит к замене вали-на на глутамат в шестом аминокислотном положении. Это повреждение заметно снижает растворимость окисленного гемоглобина S, что приводит к полимеризации окисленного гемоглобина S и деформации красных клеток крови (образованию серповидных форм) и гемолизу.
Пациенты с серповидно-клеточной анемией гомозиготны по дефективному гену и имеют гемоглобин S, но не имеют гемоглобина А. В отличие от этого, люди с характерной серповидностью клеток являются гетерозиготными по дефективному гену и имеют оба вида гемоглобина. Серповидность клеток (примерно у 1 из 10 представителей негроидной расы) обычно ничем не проявляется, но физическая активность на большой высоте, авиаперелеты и анестезия для таких людей потенциально опасны.
Клинические проявления, вытекающие из эпизодического образования серповидных форм, сводятся к микрососудистой окклюзии. Появляются болезненные приступы, когда ригидные и деформированные серповидные клетки взаимодействуют с тромбоцитами, эндотелием и факторами свертывания, вызывая нарушение микроциркуляции. Пациенты с серповидно-клеточной анемией страдают от тяжелой гемолитической анемии, которая начинается с первых недель жизни, когда гемоглобин S заменяет гемоглобин F, и длится всю жизнь. Среднее время жизни эритроцитов у этих больных составляет всего 17 дней вместо 120 в норме; таким образом, эти пациенты очень чувствительны к кратковременному угнетению функции костного мозга, вызванному разнообразными инфекциями, которые могут приводить к апластическому кризису.
Повторяющиеся эпизоды ишемического некроза приводят к прогрессирующему повреждению органов.
Лечение серповидно-клеточной анемии в прошлом было в основном поддерживающим, с использованием внутривенных вливаний жидкостей, кислородотерапии, анальгетиков для облегчения боли и переливанием крови.
Гидроксимочевина (ГМ) — это ингибитор рибонуклеотид-редуктазной системы, которая катализирует лимитирующую скорость реакции в заново реализующемся биосинтезе пуриновых и пиримидиновых дезоксирибонуклеотидов. В настоящее время ГМ используют для лечения хронической миелогенной лейкемии и истинной полицитемии. Последние клинические исследования демонстрируют, что ГМ увеличивает популяцию ретикулоцитов, содержащих гемоглобин F, и стимулирует небольшой рост уровня гемоглобина F. ГМ ослабляет болезненные приступы у тяжелобольных взрослых и у детей с серповидно-клеточной анемией. Тем не менее лечение не всегда эффективно, и у большинства пациентов приступы не ослабляются.
Еще больше клинических исследований необходимо, чтобы определить, способна ли ГМ предотвращать хронические поражения органов. Хотя ГМ широко используют в лечении разнообразных гематологических заболеваний и она относительно хорошо переносится, использование цитотоксических препаратов при незлокачественных состояниях ставит вопрос о долговременной безопасности. Клинические исследования показали, что использование ГМ в максимально допустимых дозах в течение 1 года приводит к положительным гематологическим изменениям, включая повышенную концентрацию гемоглобина с мягкой, кратковременной и обратимой интоксикацией у детей с серповидно-клеточной анемией.
Дозу гидроксимочевины следует повышать медленно до уровня, при которой проявится значительная цитопения. Рекомендованная максимальная доза составляет 10-20 мг/кг/сут.
Информация на сайте подлежит консультации лечащим врачом и не заменяет очной консультации с ним.
См. подробнее в пользовательском соглашении.
Воспалительный ответ на терапию гидроксимочевиной при серповидно-клеточной болезни
Воспалительный ответ на терапию гидроксимочевиной при серповидно-клеточной болезни
При серповидно-клеточной анемии (SCD) полимеризация гемоглобина S и, как следствие, изменение формы красные кровяных телец (эритроцитов) приводят к окклюзии сосудов и тяжелым болезненным кризам. Постоянный Воспалительное состояние и аномальная адгезия эритроцитов к эндотелию вызывают эти явления. Гидроксимочевина (HU) - единственный препарат, снижающий клиническую тяжесть ВСС, и Первоначально это было связано со стимуляцией гемоглобина плода (HbF). Тем не менее клинический ответ не коррелирует со степенью и временем увеличения HbF, предполагаемая, что клинические преимущества HU другие механизмы, такие как индукция естественный противовоспалительный ответ через систему гипоталамус-гипофиз-надпочечники.
Плазматические провоспалительные молекулы (С-реактивный белок, оросомукоид, RANTES, IL-6, IL-8, MCP-1, IL-1A, IL-1B, ET-1, IL-4, IL-10, TNFalpha, IFNgamma), гормоны из гипоталамус-гипофиз-надпочечники (кортизол, АКТГ) и гипоталамические пептиды (аргинин вазопрессин, кортикотропин-рилизинг-гормон) будет измеряться у детей с ВСС, леченных или не с HU (20 леченных детей, 20 нелеченных детей с анамнезом вазоокклюзионных событий, 20 бессимптомных детей и 20 здоровых африканцев из контрольной группы).
Тип вмешательства: Препарат, средство, медикамент
Описание: гидроксимочевина 20-25 мг / кг / день не менее 3 месяцев
Метод отбора проб:
КРИТЕРИИ ВКЛЮЧЕНИЯ: 1. Гомозиготные серповидно-клеточные дети SS в возрасте> 3 лет, происходящие из Африки к югу от Сахары, в устойчивом состоянии болезни (без каких-либо инфекционных или вазоокклюзионных событий для 4 недели до и 2 недели после забора крови, без переливания в течение 4 месяцев перед забором крови), не принимал никаких лекарств, кроме пенициллина-V, фолиевой кислоты или железа Добавки гидроксимочевины делятся на три группы: - детям, получавшим гидроксимочевину 20-25 мг / кг / день в течение не менее 3 месяцев с клиническая эффективность в отношении вазоокклюзионных явлений - нелеченные дети с серьезными вазоокклюзионными событиями - дети старше 5 лет без вазоокклюзионных явлений в анамнезе Подпись проинформирована согласие испытуемых (если возможно) и их родителей 2. Контроль: гетерозиготные родители или братья и сестры пациентов с АА, а также братья и сестры от АА или здоровые африканские неродственные субъекты в возрасте> 3 лет, не принимавшие никаких лекарств в день сдачи крови отбор проб. Подписанное информированное согласие, полученное от субъектов (если возможно) и их родителей. КРИТЕРИЙ ИСКЛЮЧЕНИЯ: - Дети в острой фазе заболевания - Отказ родителя или пациента - Прием любых препаратов, кроме пенициллина-V, добавок фолиевой кислоты или железа, гидроксимочевины. - Нездоровый контроль или прием наркотиков
Принимает здоровых добровольцев
Метка: Homozygous SS sickle cell children
Описание: Hydroxycarbamide, Hydroxyurea (drug): Homozygous SS sickle cell children, aged > 3 years, of sub-Saharian Africa extraction, in a steady-state of disease , taken no drug except penicillin-V, folate or iron supplementation, hydroxyurea, divided into three groups : children treated with hydroxyurea 20-25 mg/kg/day since at least 3 months with clinical efficacy on vaso-occlusive events untreated children with major vaso-occlusive events children > 5 year-old without a history of vaso-occlusive events Controls : heterozygous AS parents or siblings of the patients, and AA siblings or healthy African unrelated subjects, aged > 3 years, taken no drug on the day of blood sampling.
Метка: Гомозиготные дети СС
Описание: Гидроксикарбамид, гидроксимочевина (лекарственное средство): Гомозиготные дети SS в возрасте> 3 лет, происходящие из Африки к югу от Сахары, в стабильном состоянии болезни, не принимавшие никаких лекарств, кроме пенициллина-V, фолиевой кислоты или добавок железа, гидроксимочевины, разделенных на три группы: дети, получавшие гидроксимочевину 20-25 мг / кг / день по крайней мере с 3 месяцев с клинической эффективностью при вазоокклюзионных событиях нелеченные дети с серьезными вазоокклюзионными событиями дети старше 5 лет без вазоокклюзионных событий в анамнезе Контроль: гетерозиготные родители или братья и сестры пациентов с АА, а также братья и сестры из группы АА или здоровые африканские неродственные субъекты в возрасте> 3 лет, не принимавшие никаких лекарств в день забора крови.
This information was retrieved directly from the website clinicaltrials.gov without any changes. If you have any requests to change, remove or update your study details, please contact [email protected] . As soon as a change is implemented on clinicaltrials.gov, this will be updated automatically on our website as well.
Гидроксимочевина поможет избежать сердечных осложнений у пациентов с серповидно-клеточной анемией
Поражения сердца являются распространенными осложнениями серповидноклеточной анемии (СКA), которые могут способствовать тяжелым симптомам заболевания и даже смерти. Исследование, недавно опубликованное в журнале Blood Advances и на медицинском портале Medical Xpress, является первым, которое показало, что терапия гидроксимочевиной может улучшить или даже обратить вспять сердечные осложнения у людей, живущих с СКA 1 .
Считается, что гидроксимочевина, один из четырех препаратов, в настоящее время одобренных Управлением по контролю за продуктами и лекарствами США для лечения СКА, смягчает симптомы СКА, предотвращая образование серповидных клеток, но точный механизм ее действия до сих пор до конца не изучен.
Исследователи оценили данные 100 детей и молодых взрослых (в возрасте от 3 до 22 лет), получающих помощь по поводу СКА в рамках Детской серповидноклеточной программы Детского медицинского центра Коэна в Нью-Йорке. У половины участников исследования было обнаружено увеличение или утолщение стенки левого желудочка (ЛЖ) сердца. Также у части пациентов были выявлены признаки легочной гипертензии.
Шестьдесят участников исследования принимали гидроксимочевину, и исследователи отметили, что у этой группы пациентов не было разницы в степени увеличения ЛЖ по сравнению с группой, не принимавшей препарат. Однако, они обнаружили, что сердечные исходы были лучше у лиц, принимавших гидроксимочевину в течение более длительного времени.
"Когда мы сравнили группу, которая лечилась гидроксимочевиной менее одного года, с группой, которая лечилась более одного года, мы обнаружили, что у пациентов, которые лечились дольше, был меньше риск гипертрофии отделов сердца" , - сказал один из исследователей. "Это открытие подготовило почву для следующего этапа нашего исследования, где мы обнаружили улучшение ряда показателей сердечной деятельности при приеме гидроксимочевины".
Соответственно, следующим этапом исследования был продольный анализ, в ходе которого исследователи оценивали результаты эхокардиограмм, выполняемых у пациентов, получавших лечение гидроксимочевиной. Они обнаружили, что чем дольше пациент принимал гидроксимочевину, тем меньше у него был риск увеличения размеров или утолщения стенки ЛЖ . Было выявлено 34 пациента, у которых при первом обследовании была выявлена аномальная масса ЛЖ, из них у 18 масса ЛЖ нормализовалась при их последнем посещении.
По мнению исследователей, полученные результаты подчеркивают необходимость раннего скрининга сердечных нарушений, связанных с серповидноклеточными заболеваниями, даже у бессимптомных пациентов, чтобы можно было выявить любые отклонения на ранней стадии и как можно быстрее начать лечение гидроксимочевиной.
Исследование имело ряд ограничений: ретроспективный характер и тот фактом, что эхокардиограммы, оцененные в ходе исследования, не оценивали дополнительные параметры функции сердца, такие как диастолическая функция. "Мы планируем проспективное исследование, в котором будем мониторировать состояние пациентов, принимающих гидроксимочевину, в течение более длительного времени, даже в зрелом возрасте, когда состояние сердечно-сосудистой системы ухудшается", - сказал один из авторов.
Серповидноклеточную анемию предложили лечить «раздуванием» эритроцитов

Американские ученые разработали систему скрининга деформации эритроцитов при серповидноклеточной анемии. С ее помощью они обнаружили, что вещества, увеличивающие объем клеток, предотвращают их деформацию. Результаты работы опубликованы в журнале Proceedings of the National Academy of Sciences.
Серповидноклеточная анемия — это наследственное заболевание, обусловленное одиночной мутацией в гене бета-субъединицы гемоглобина (белковая часть гемоглобина состоит из двух альфа- и двух бета-субъединиц). Из-за этого дефектный гемоглобин (HbS), отдавая тканям кислород, полимеризуется с образованием волокон, которые деформируют эритроциты, придавая им серповидную форму. Такие эритроциты хуже проходят через мелкие сосуды, что приводит к образованию тромбов, а также быстрее разрушаются, из-за чего возникает анемия.
Единственное лекарство, применяемое сейчас при серповидноклеточной анемии, это гидроксимочевина. Она способствует синтезу младенческой (фетальной) формы гемоглобина, которая снижает концентрацию HbS и замедляет его полимеризацию, позволяя большему числу клеток проходить через микрососудистое русло. Однако гидроксимочевина действует не на все клетки, что ограничивает ее действенность. Кроме того, она обладает множеством побочных эффектов.
С помощью этой системы ученые провели скрининг потенциальных лекарственных препаратов. Они обнаружили, что два ионофора — грамицидин А и монензин А — подавляют деформацию эритроцитов, увеличивая их объем и не давая HbS достичь критической для полимеризации концентрации. Потенциальным осложнением увеличения объема клеток может стать их разрушение (гемолиз), однако при минимально эффективной концентрации препаратов (менее 800 пикомоль на литр для грамицидина А и менее 10 наномоль на литр для монензина А) его не наблюдалось.
Также ученые использовали систему для проверки эффективности двух экспериментальных препаратов — AES-103 и GBT440, которые сейчас проходят клинические испытания при серповидноклеточной анемии. Предположительно они подавляют полимеризацию HbS за счет повышения его сродства к кислороду. Анализ показал, что этот механизм действия является единственным для AES-103 — в отсутствие кислорода это вещество не производило эффекта даже в концентрации три миллимоль на литр. GBT440 оказался эффективным в концентрации 30 микромоль на литр. Такая концентрация превышает терапевтическую, однако, по мнению исследователей, эффективность препарата можно повысить путем небольших модификаций его молекулы.
Недавно был разработан и испытан на мышах и человеческих клетках метод лечения серповидноклеточной анемии, основанный на технологии редактирования генома CRISPR/Cas9 (подробнее о ней можно почитать здесь). Однако такое лечение даже в случае успеха клинических испытаний будет весьма дорогим и недоступным большинству пациентов.
Серповидно-клеточная анемия. Причины, симптомы, диагностика и лечение серповидно-клеточной анемии.
1. Что такое серповидно-клеточная анемия и ее причины
Серповидно-клеточная анемия – это наследственное заболевание крови. Попробуем разобраться, в чем же оно заключается. Эритроциты крови содержат гемоглобин – белок, который переносит кислород в крови. В норме эритроциты имеют круглую форму и они гибкие, что позволяет им двигаться через мелкие кровеносные сосуды, чтобы доставить кислород ко всем частям тела.
Серповидно-клеточная анемия заставляет клетки крови принимать форму полумесяца, или серпа. В такой форме клеток крови эритроциты очень легко распадаются, что вызывает анемию. Серповидные красные клетки живут всего 10-20 дней вместо 120 дней, как бывает в норме у здоровых клеток. Кроме того, поврежденные эритроциты слипаются и прилипают к стенкам кровеносных сосудов, блокируя поток крови. Это может стать причиной сильных болей и постоянного повреждения мозга, сердца, легких, почек, печени, костей и селезенки.
Причины серповидно-клеточной анемии
Серповидно-клеточная анемия человека вызывается генетической аномалией в гене гемоглобина. Эта аномалия приводит к появлению серповидного гемоглобина. Когда кислород высвобождается от серповидного гемоглобина, он склеивается и образует длинные стержни, которые повреждают эритроцит и изменяют его форму. Серповидные эритроциты и вызывают симптомы серповидно-клеточной анемии.
Серповидно-клеточная анемия человека не заразна. Это генетическое заболевание, с которым рождается человек. Заболевание развивается, когда ребенок наследует два аномальных гена гемоглобина, по одному от каждого из родителей. Люди, которые унаследовали только один аномальный ген гемоглобина, являются его носителями, но у них не будет анемии и симптомов этого заболевания.
2. Симптомы заболевания
Симптомами серповидно-клеточной анемии могут быть:
- Сильные боли;
- Анемия;
- Боль в груди и затрудненное дыхание;
- Боль в суставах, артрит;
- Закупорка кровотока в селезенке или печени;
- Тяжелые инфекции.
У больных серповидно-клеточной анемией развивается тяжелая боль в груди, спине, руках, ногах и животе. Кроме того, боль может возникать в любой части тела. Серповидные красные кровяные клетки в легких могут вызвать серьезные заболевания с такими симптомами, как боль в груди, лихорадка и затрудненное дыхание. Серповидно-клеточная анемия может привести и к необратимым повреждениям мозга, сердца, почек, печени, селезенки и костей. Ососбенность этого заболевания в том, что тяжесть и симптомы болезни могут сильно отличаться у разных людей, даже если они являются кровными родственниками.
3. Диагностика серповидно-клеточной анемии
Серповидные эритроциты можно увидеть, когда образец крови исследуется под микроскопом. Но для диагностики серповидно-клеточной анемии человека используется специальный анализ крови – гемоглобин-электрофорез, который позволяет измерить количество аномального гемоглобина. В зависимости от установленного количества серповидного гемоглобина можно определить, является ли человек носителем гена или имеет заболевание серповидно-клеточную анемию.
Есть и быстрые скрининг-тесты, которые помогают выявить серповидные эритроциты или сгустки аномального гемоглобина, когда кислород выходит из крови. Но эти тесты применяются редко, потому что они не позволяют отличить заболевание и простое наличие гена болезни.
Перинатальная диагностика серповидно-клеточной анемии проводится путем изучения ДНК клеток плода, полученных при биопсии хориона или амниоцентеза.
4. Лечение болезни
Для лечения серповидно-клеточной анемии человека применяются:
- Опиоидные обезболивающие (например, морфин);
- Противовоспалительные препараты (например, ибупрофен);
- Антибиотики для лечения инфекций;
- Кислород;
- Внутривенное или пероральное введение специальных жидкостей.
Переливание эритроцитов может понадобиться в случае тяжелой анемии, для профилактики приступов стенокардии или перед операцией. Иногда обменное переливание осуществляется с помощью специального аппарата, который удаляет серповидные красные кровяные клетки и заменяет их на здоровые.
Для лечения серповидно-клеточной анемии может назначаться специальный препарат – гидроксимочевина. Он помогает предотвратить приступы боли. Исследования показали, что при регулярном приеме гидроксимочевины у больных серповидно-клеточной анемией уменьшается частота и тяжесть приступов боли, а также сокращается количество необходимых переливаний крови и госпитализаций.
Единственным способом действительно вылечить серповидно-клеточную анемию человека является пересадка стволовых клеток. Это достаточно новый метод лечения. Он сопряжен с серьезными рисками (около 5-10% риск смертельного исхода), но те пациенты, трансплантация стволовых клеток у которых прошла успешно, полностью вылечились от серповидно-клеточной анемии.
Пересадка стволовых клеток обычно делается молодым пациентам с тяжелой серповидно- клеточной анемией, для которых удается подобрать подходящего донора. Иногда для трансплантации стволовых клеток используется пуповинная кровь от донора-родственника.
Важно и то, что ученые постоянно изучают возможность лечения серповидно-клеточной анемии человека с помощью новых препаратов, которые предотвращают выработку серповидно- клеточных эритроцитов красных кровяных клеток и улучшают кровоток и доставку кислорода к органам и тканям. И эти новые методы лечения уже довольно успешно проходят тестовые испытания.
Вообще люди с серповидно-клеточной анемией, как правило, имеют меньшую продолжительность жизни. Но современная медицина показывает неплохие результаты. Современные методики лечения позволяют существенно продлить жизнь таким пациентам.В 1973 году средняя продолжительность жизни людей с серповидно-клеточной анемией была 14 лет, а сегодня цифра 40-50 лет является вполне реальной. Бывает, что пациенты живут 60 лет и дольше. Постоянное лечение гидроксимочевиной может продлить жизнь.
Читайте также:
